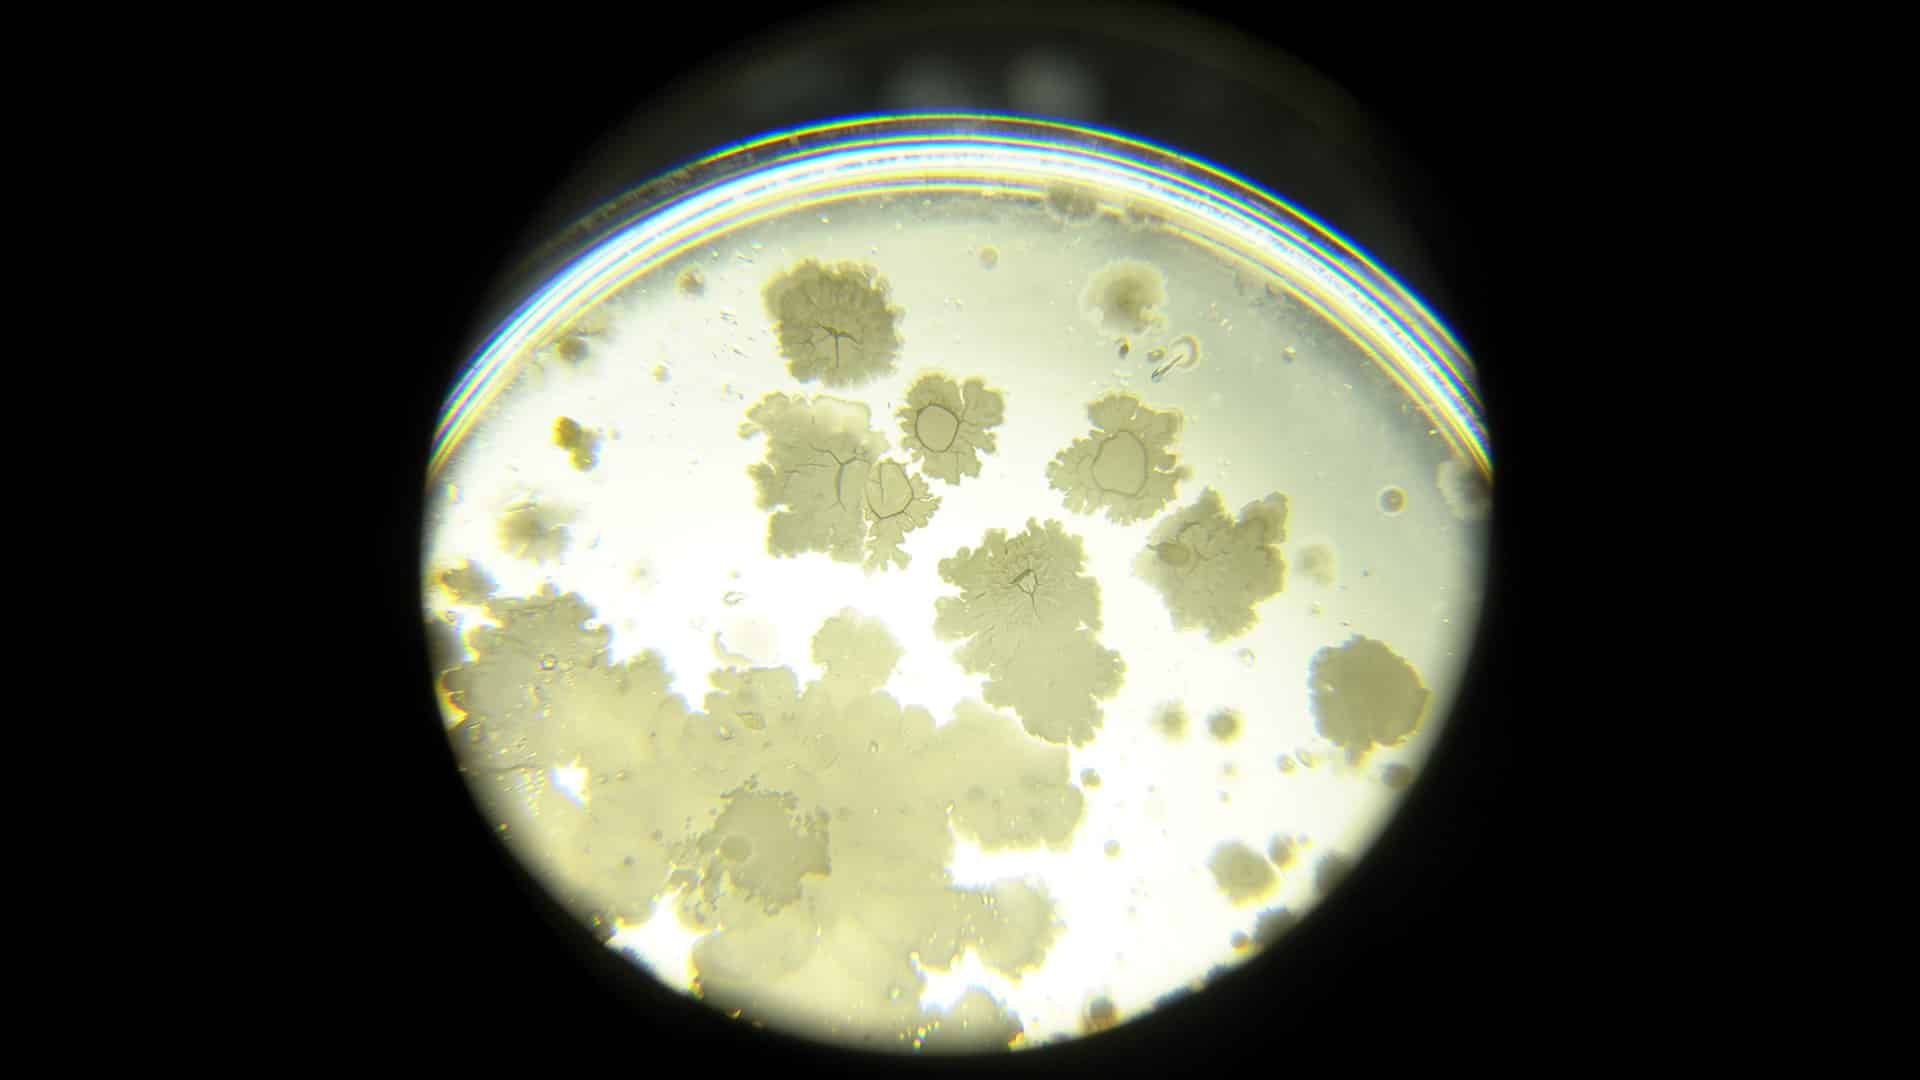

Este año, 24 artistas, pensadores, curadores, investigadores de las ciencias exactas, sociales y humanidades, científicos y tecnólogos participaron del programa organizado por Fundación Bunge y Born y Fundación Williams.
Los participantes de Chaco, Córdoba, San Juan, Santa Fe, Río Negro, Tucumán, Buenos Aires y CABA, presentarán seis proyectos finales.
Los grupos abordaron, en forma interdisciplinaria, el uso e impacto de nuevas tecnologías como la Inteligencia Artificial, la edición genética, perspectivas no-humanas, entre otras. La inversión anual fue de 45 millones de pesos.
La exposición abrirá sus puertas el jueves 27 de noviembre, de 19 a 22 horas, y permanecerá abierta hasta el domingo 30 de noviembre, de 16 a 20 horas, en Fundación Cazadores (Villarroel 1438, Villa Crespo, CABA).
En 2025, visitaron el programa tres referentes internacionales: Heather Dewey-Hagborg (Estados Unidos), Juan Cortés (Colombia) y Daniel Canogar (España, Estados Unidos), quienes brindaron workshops para los becarios y clases magistrales abiertas al público.
Presente Continuo es un programa federal de formación interdisciplinaria, con una duración de dos años, para la producción de obras, ideas, descripciones y narrativas. Está destinado a artistas, pensadores, curadores, investigadores de las ciencias exactas, sociales y humanidades, científicos y tecnólogos de todo el país. Es organizado por Fundación Bunge y Born y Fundación Williams, y cuenta además con la colaboración de Fundación Andreani y el Centro Cultural de España en Buenos Aires (CCEBA).
EL PROGRAMA
Durante el primer año del programa los becarios participan de un espacio de formación y producción con referentes en la vanguardia global, con quienes analizan y discuten el futuro del arte y el devenir de la humanidad en un mundo atravesado por la tecnología y su impacto en distintas problemáticas.
En simultáneo, durante siete meses, trabajan en el diseño y prototipado de obras, para los que el programa dispuso de un presupuesto de más de $45.000.000, distribuidos en becas y subsidios, que se otorgaron directamente a los participantes para apoyar la producción y la realización de los proyectos. Se conformaron grupos que abordaron, en forma interdisciplinaria, el uso e impacto de nuevas tecnologías como la Inteligencia Artificial, la edición genética, perspectivas no-humanas, entre otras.
«El programa se consolida como un ámbito de formación y vinculación donde talentos de todo el país interactúan con referentes internacionales. Al facilitar luego residencias en el exterior, el programa actúa como catalizador para la producción de obras renovadoras y de alto impacto», explica Martín Oliver, director Ejecutivo de Fundación Williams.
En tanto, el director de Cultura y Ciencia de la Fundación Bunge y Born, Iván Petrella, sostiene: “Invitamos a referentes internacionales que están en la vanguardia del cruce entre arte, ciencia y tecnología para que con los artistas, científicos y tecnólogos locales podamos pensar y producir en conjunto respuestas posibles a los interrogantes del momento”.
EXPOSICIÓN 2025
Abrirá sus puertas el jueves 27 de noviembre de 19 a 22 horas, y estará abierto el viernes 28, sábado 29 y domingo 30 de noviembre, de 16 a 20 horas, en Fundación Cazadores (Villarroel 1438, Villa Crespo, CABA).
LOS SEIS PROYECTOS EXPUESTOS
Nunca fuimos individuos
Integrantes: Penny Di Roma, Matias Jauregui Lorda, Antonella Mecchia y Angel Salazar.
Los cambios tecnológicos modifican la percepción de tiempo y espacio, acelerando los procesos terrestres y las crisis socioambientales. Esta instalación se propone hacer tangible la velocidad y la escala tecno-industrial a partir de ensayar ritmos alternativos en cadenas tróficas o en los cultivos que desafían las lógicas productivistas. La obra performa conversaciones posibles, borroneando las dicotomías naturaleza/cultura, cuerpo/mente, individuo/grupo, e invita a explorar cómo se modulan los afectos, los sentidos y la política desde una perspectiva en disputa. Las prácticas artísticas pueden tomar procedimientos prestados que no sean ni diacrónicos, ni distópicos, sino radicalmente desaceleracionistas.

Fenomenología de una opacidad
Integrantes: Laura Colombo, Celeste Massin, Manuel Quaranta y Elias Sarquis.
Es una instalación escultórica y performática que interroga lo que permanece oculto en la materia tecnológica; la energía que persiste tras el colapso y el deseo —humano, arcaico— de volver a acceder a lo que ya no comprendemos. En la exposición, un gran volumen negro se impone con su presencia densa y silenciosa. A su alrededor habrá un conjunto de herramientas rudimentarias -fabricadas con restos electrónicos y metales- que sugiere la posibilidad de una acción: romper, intervenir, abrir. Los visitantes podrán usarlas. Una vez destruida la primera capa quedará al descubierto la imposibilidad de penetrar la segunda y ese gesto físico-simbólico constituye el núcleo del proyecto. La obra dramatiza la lógica de la caja negra, la condición contemporánea de nuestra relación con las tecnologías: el choque con el límite y la constatación de que el deseo se convierte, finalmente, en una poética del fracaso.

Instrucciones para una obra
Integrantes: Paula Bruno Garcén, Oliverio Duhalde, Lihuel González e Ignacio Unrrein.
El proyecto investiga y materializa una performance escénica y un audiovisual donde los roles de autoría, dirección e interpretación se ponen en crisis mediante la participación activa de una inteligencia artificial como dramaturga y directora. La obra propone una escena en la que los cuerpos humanos se ponen al servicio de ideas generadas por una máquina. En lugar de que los artistas utilicen la IA como herramienta, es la propia inteligencia artificial quien diseña el esquema conceptual y escénico de la obra. La pieza audiovisual registra los encuentros con la IA-directora, mientras que los intérpretes en escena ejecutan instrucciones y representan imágenes, escenas y tensiones. La propuesta surge del cruce entre performance y nuevas tecnologías, atendiendo a las preguntas éticas, políticas y estéticas que emergen de esta relación.
Latencia
Integrantes: Javier Areal Vélez, Candela Del Valle, Enzo Luciano y Luciana Paoletti.
Se trata de una red de comunicación lateral y no intencional de entidades vivas. Ante las dificultades de consensuar entre humanxs mediante el lenguaje, la obra crea un nuevo medio de paracomunicación para habilitar intercambios entre microorganismos que habitan nuestros cuerpos. Estas relaciones no son verbales, sino reacciones orgánicas que se vinculan, se transforman y siguen modificándose en el tiempo. La propuesta invita a pensarnos como territorios, seres compuestos, sistemas interespecies que sobreviven por complementariedad.
Ermita
Integrantes: Jorge Crowe, Cecilia Marina Luján, Mecha MIO y Federico Ezequiel Salgado.
En toda tecnología existe algo de magia, algo que no se puede ver ni entender. Ermita es una invitación a contemplar nuestro vínculo intenso con el celular, agente que media una gran parte de las relaciones humanas con el entorno. Se trata de una experiencia audiovisual a partir de las ondas electromagnéticas irradiadas por el celular, capturadas y transformadas en vibraciones sonoras. La pantalla del teléfono se disuelve en pura luz. Luz y electromagnetismo en su dualidad entre la materia y lo impalpable, entre lo real y lo abstracto. Este trabajo vuelve tangible aquello que no percibimos sino a través de la tecnología. Como dos estratos de existencia: la que percibimos con nuestros sentidos y otra mediada por la tecnología.

Todo ya existe
Integrantes: Fabiana Gallegos, Fernanda Mugica, Facundo Suasnabar y Fabián Urban.
El proyecto aborda las nociones de vacío y límite como relatos persistentes que legitimaron procesos de apropiación, colonización y extractivismo. A partir de la forma topográfica de la una zanja y de capas contemporáneas —como la minería del carbón o la hidrofractura— se construye un mapa audiovisual especulativo donde se entrelazan pasado, presente y futuros posibles. Estas capas actúan como palimpsestos que revelan tensiones geológicas, históricas y afectivas, proponiendo una lectura expandida del territorio como trama de memorias, conflictos y persistencias.

ARTISTAS INTERNACIONALES 2025
Heather Dewey-Hagborg es una artista y biohacker con sede en Nueva York, interesada en el arte como investigación y en la crítica tecnológica. Su controvertida práctica artística biopolítica incluye el proyecto Stranger Visions, en el que creó esculturas de retratos a partir del análisis de material genético (cabello, colillas de cigarrillos, chicles masticados) recolectado en espacios públicos.
Juan Cortés se graduó en Artes Plásticas con especialización en medios audiovisuales de la Universidad de los Andes en 2012. Su obra se centra en la intersección entre arte, ciencia y naturaleza, explorando fenómenos naturales y fuerzas invisibles a través de instalaciones, grabaciones y piezas de concierto.
Daniel Canogar. Nacido en Madrid (1964), hijo de madre estadounidense y padre español, la vida y carrera de Daniel Canogar se han dividido entre España y Estados Unidos. La fotografía fue su primer medio de elección, aunque pronto se interesó por las posibilidades de la imagen proyectada y la instalación artística.
EDICIONES PASADAS
En las dos primeras ediciones participaron 60 artistas, tecnólogos e investigadores de todo el país, quienes asistieron a las masterclasses y workshops que dieron en Buenos Aires tres visitas internacionales de primer nivel, que trabajan temas de la cuarta revolución tecnológica: realidad aumentada, inteligencia artificial, medios locativos, bioarte, edición génica, entre otros.
Pasaron por el programa Maurice Benayoun, Guto Nóbrega, Rafael Lozano Hemmer, Marcela Armas, Oscar Santillán y Mónica Bello.
Los participantes de estas ediciones pudieron participar en 2024 y 2025 de una serie de residencias en instituciones socias del programa, tales como TBA21 de España, la Universidad Federal de Río de Janeiro, Brasil; la Universidad de los Andes de Bogotá y la Universidad del Valle de Cali, ambas de Colombia, y Núcleo Milenio FAIR, de la Universidad Católica de Chile.








